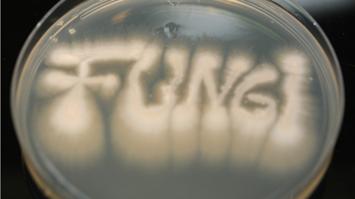
Pilz unter Mikroskop

Mitmachstation
AI Wonderland with Dynatrace
Thema:
Digitalisierung
Schlagworte:
Künstliche Intelligenz
Altersgruppe:
Alle
Zielgruppe:
Barrierefrei, In English und für Gruppen & Schulklassen
Maximale Kapazität der Station: 20 Personen
In AI Wonderland, you can experience the fascination of Artificial Intelligence for yourself and learn how technology is transforming our world.
Visitors can design their own cool game, and get to know the fascinating possibilities of AI and modern technology in a fun way. This program sparks curiosity and amazement in young and old, inviting everyone to join in, learn, and get creative. Perfect for anyone excited about technology and innovation!
Besucherinformation
Dieser Ausstellungsstandort ist barrierefrei zugänglich und verfügt über barrierefreie Toiletten.
Dynatrace Austria GmbH
Dynatrace
CCB - Centrum für Chemie und Biomedizin
Innrain 80 - 82, 6020 Innsbruck
Öffnungszeiten
Erster Einlass: 17:00
Letzter Einlass: 23:00
Kontakt
Information
- SH1 - Linie Innsbruck (PDF, 289.40 KB)
- Routenplan Shuttlebusse SH 1 & SH2 (PDF, 679.03 KB)
- Standorte LNF26 (PDF, 716.73 KB)
- IVB Shuttle - SH 1 Linie Innsbruck (PDF, 289.76 KB)
- IVB Shuttle - SH 2 Linie Hall (PDF, 288.79 KB)
- Standorte LNF 2026 (PDF, 716.73 KB)
- IVB Routen Innsbruck und Hall (PDF, 679.03 KB)
75 weitere Stationen an diesem Standort
-
 MitmachstationNovartis -Mittendrin statt nur dabei – Wie funktionieren Spritzen, Pens und Autoinjektoren?Thema: Gesundheit NaturwissenschaftenSpritzen, Pens und Autoinjektoren gehören zu den sogenannten Kombinationsprodukten – Medizinprodukte, die ein Arzneimittel sicher verabreichen.Novartis Österreich17:00 - 23:00
MitmachstationNovartis -Mittendrin statt nur dabei – Wie funktionieren Spritzen, Pens und Autoinjektoren?Thema: Gesundheit NaturwissenschaftenSpritzen, Pens und Autoinjektoren gehören zu den sogenannten Kombinationsprodukten – Medizinprodukte, die ein Arzneimittel sicher verabreichen.Novartis Österreich17:00 - 23:00 -
 MitmachstationNovartis - Harry Potter: Die Suche nach dem/der Fälscher:inThema: Gesundheit WirtschaftAnalytische Detektive gesucht! In dieser aufregenden magischen Herausforderung liegt das Schicksal von Harry Potter in euren Händen.Novartis Österreich17:00 - 23:00
MitmachstationNovartis - Harry Potter: Die Suche nach dem/der Fälscher:inThema: Gesundheit WirtschaftAnalytische Detektive gesucht! In dieser aufregenden magischen Herausforderung liegt das Schicksal von Harry Potter in euren Händen.Novartis Österreich17:00 - 23:00 -
 Experiment / VorführungNovartis - Was haben Frühstückseier, Haare, Leim und Seidenhemden gemeinsam?Thema: Gesundheit NaturwissenschaftenPuzzeln für Wissenschaftler:innen: Massenspektrometrie von EiweißenNovartis Österreich17:00 - 23:00
Experiment / VorführungNovartis - Was haben Frühstückseier, Haare, Leim und Seidenhemden gemeinsam?Thema: Gesundheit NaturwissenschaftenPuzzeln für Wissenschaftler:innen: Massenspektrometrie von EiweißenNovartis Österreich17:00 - 23:00 -
 MitmachstationNovartis - Wissenschaftliches Farbenspiel: Entdecke die faszinierende Welt der analytischen TrennverfahrenThema: Gesundheit NaturwissenschaftenEntdecke die faszinierende Welt der Farben und lerne spielend bei unserem "Farbauftrennungsexperiment", wie analytische Trennverfahren zur Aufreinigung funktionieren.Novartis Österreich17:00 - 23:00
MitmachstationNovartis - Wissenschaftliches Farbenspiel: Entdecke die faszinierende Welt der analytischen TrennverfahrenThema: Gesundheit NaturwissenschaftenEntdecke die faszinierende Welt der Farben und lerne spielend bei unserem "Farbauftrennungsexperiment", wie analytische Trennverfahren zur Aufreinigung funktionieren.Novartis Österreich17:00 - 23:00 -
 MitmachstationNovartis - Virtuelle Site Tour: Begleite uns in die spannende Welt der MedikamentenherstellungThema: Digitalisierung GesundheitBegleiten Sie uns in die spannende Welt der modernen Biopharmazeutika-Herstellung!Novartis Österreich17:00 - 23:00
MitmachstationNovartis - Virtuelle Site Tour: Begleite uns in die spannende Welt der MedikamentenherstellungThema: Digitalisierung GesundheitBegleiten Sie uns in die spannende Welt der modernen Biopharmazeutika-Herstellung!Novartis Österreich17:00 - 23:00 -
 ShowprogrammOroboros Instruments GmbH: Wie wirken Medikamente auf molekulare Maschinen (Proteine) und die Energiekraftwerke unserer Zellen (Mitochondrien)?Thema: Gesundheit NaturwissenschaftenMitochondrien (Zellkraftwerke) und Proteine (molekulare Maschinen) sind zentral für den Körper. Oroboros Instruments und KinCon biolabs kombinieren ihre Technologien zur Analyse von Mitochondrien und krankheitsrelevanten Proteinen, um Arzneimittelentwicklung präziser, schneller und sicherer zu machen und Nebenwirkungen früh zu erkennen und zu minimieren. Das fördert Diagnose und Verständnis vieler Krankheiten.Oroboros Instruments GmbH17:00 - 23:00
ShowprogrammOroboros Instruments GmbH: Wie wirken Medikamente auf molekulare Maschinen (Proteine) und die Energiekraftwerke unserer Zellen (Mitochondrien)?Thema: Gesundheit NaturwissenschaftenMitochondrien (Zellkraftwerke) und Proteine (molekulare Maschinen) sind zentral für den Körper. Oroboros Instruments und KinCon biolabs kombinieren ihre Technologien zur Analyse von Mitochondrien und krankheitsrelevanten Proteinen, um Arzneimittelentwicklung präziser, schneller und sicherer zu machen und Nebenwirkungen früh zu erkennen und zu minimieren. Das fördert Diagnose und Verständnis vieler Krankheiten.Oroboros Instruments GmbH17:00 - 23:00 -
 Experiment / VorführungAdler Lacke: Kann man Lack mit 5 Sinnen erleben?Thema: Naturwissenschaften TechnikTauchen Sie ein in die faszinierende Welt des Lacks und erleben Sie ihn mit allen fünf Sinnen! An unserer Station entdecken Sie, wie Lack aussieht, sich anfühlt, riecht, klingt und sogar wie er auf Umgebungen reagiert. Interaktive Experimente machen sichtbar, was sonst verborgen bleibt – von haptischen Oberflächen bis hin zu spannenden Materialeffekten.ADLER-Werk Lackfabrik Johann Berghofer GmbH & Co KG17:00 - 23:00
Experiment / VorführungAdler Lacke: Kann man Lack mit 5 Sinnen erleben?Thema: Naturwissenschaften TechnikTauchen Sie ein in die faszinierende Welt des Lacks und erleben Sie ihn mit allen fünf Sinnen! An unserer Station entdecken Sie, wie Lack aussieht, sich anfühlt, riecht, klingt und sogar wie er auf Umgebungen reagiert. Interaktive Experimente machen sichtbar, was sonst verborgen bleibt – von haptischen Oberflächen bis hin zu spannenden Materialeffekten.ADLER-Werk Lackfabrik Johann Berghofer GmbH & Co KG17:00 - 23:00 -
 MitmachstationAnalytische Chemie: Das Verborgene sichtbar machen!“Thema: Naturwissenschaften UmweltTauchen Sie ein in die Welt der Analytischen Chemie und erleben Sie, wie sie uns hilft, Stoffe zu identifizieren und zu trennen. Bei uns können Sie Blattfarbstoffe auftrennen, magische Farbwechsel beobachten und bunte Flammen erzeugen. Als Highlight versilbern Sie selbst ein Glas. Wir zeigen, wie diese Methoden in Forschung und Entwicklung eingesetzt werden.Universität Innsbruck17:00 - 23:00
MitmachstationAnalytische Chemie: Das Verborgene sichtbar machen!“Thema: Naturwissenschaften UmweltTauchen Sie ein in die Welt der Analytischen Chemie und erleben Sie, wie sie uns hilft, Stoffe zu identifizieren und zu trennen. Bei uns können Sie Blattfarbstoffe auftrennen, magische Farbwechsel beobachten und bunte Flammen erzeugen. Als Highlight versilbern Sie selbst ein Glas. Wir zeigen, wie diese Methoden in Forschung und Entwicklung eingesetzt werden.Universität Innsbruck17:00 - 23:00 -
 MitmachstationBiomystery: Wie werden Laborwerte in Blutproben ermittelt?Thema: Gesundheit NaturwissenschaftenTauchen Sie ein in unseren Mini-Biomystery-Escape-Room und erleben Sie Laborarbeit spielerisch. Finden Sie durch spannende Rätsel heraus, wie moderne Methoden wie Chromatographie und Massenspektrometrie zur Lösung des Patientenfalls beitragen.Medizinische Universität Innsbruck17:00 - 23:00
MitmachstationBiomystery: Wie werden Laborwerte in Blutproben ermittelt?Thema: Gesundheit NaturwissenschaftenTauchen Sie ein in unseren Mini-Biomystery-Escape-Room und erleben Sie Laborarbeit spielerisch. Finden Sie durch spannende Rätsel heraus, wie moderne Methoden wie Chromatographie und Massenspektrometrie zur Lösung des Patientenfalls beitragen.Medizinische Universität Innsbruck17:00 - 23:00 -
 Experiment / VorführungFaszination Analytischen ChemieThema: Naturwissenschaften UmweltMit modernen analytischen Methoden werden Stoffe aus Medizin, Umwelt und Pflanzenforschung sichtbar gemacht. Der Vortrag zeigt allgemein verständlich, wie Biomoleküle, Naturstoffe und Umweltproben mithilfe schneller Trennverfahren und spektroskopischer Techniken untersucht und für Diagnostik, Umweltanalytik und Forschung genutzt werden.Universität Innsbruck17:00 - 23:00
Experiment / VorführungFaszination Analytischen ChemieThema: Naturwissenschaften UmweltMit modernen analytischen Methoden werden Stoffe aus Medizin, Umwelt und Pflanzenforschung sichtbar gemacht. Der Vortrag zeigt allgemein verständlich, wie Biomoleküle, Naturstoffe und Umweltproben mithilfe schneller Trennverfahren und spektroskopischer Techniken untersucht und für Diagnostik, Umweltanalytik und Forschung genutzt werden.Universität Innsbruck17:00 - 23:00 -
 Experiment / VorführungForever Young? Der Traum vom Jungbrunnen im molekularen ZeitalterThema: Gesundheit NaturwissenschaftenWie können reprogrammierte Stammzellen helfen, Krankheiten wie Parkinson, Alzheimer, Autismus oder Schizophrenie besser zu verstehen – oder sogar zu heilen? Können wir Stammzellen und künstlicher Intelligenz das Gehirn verjüngen oder Organe im Labor züchten? Entdecken Sie die Welt der Stammzellforschung: erleben Sie Mitmachstationen, sprechen Sie mit Forschenden und gewinnen Sie beim Stammzell-Quiz!Universität Innsbruck17:00 - 23:00
Experiment / VorführungForever Young? Der Traum vom Jungbrunnen im molekularen ZeitalterThema: Gesundheit NaturwissenschaftenWie können reprogrammierte Stammzellen helfen, Krankheiten wie Parkinson, Alzheimer, Autismus oder Schizophrenie besser zu verstehen – oder sogar zu heilen? Können wir Stammzellen und künstlicher Intelligenz das Gehirn verjüngen oder Organe im Labor züchten? Entdecken Sie die Welt der Stammzellforschung: erleben Sie Mitmachstationen, sprechen Sie mit Forschenden und gewinnen Sie beim Stammzell-Quiz!Universität Innsbruck17:00 - 23:00 -
 MitmachstationFortschritt durch Licht: Wie Treibhausgase nützlich werden!Thema: Naturwissenschaften UmweltDer Klimawandel ist eines der gravierendsten Probleme unserer Gegenwart. Umso wichtiger ist es, Wege zu finden, Treibhausgase wie Kohlenstoffdioxid (CO₂) oder das stärkste bekannte Treibhausgas Schwefelhexafluorid (SF₆) in etwas Nützliches umzuwandeln.Universität Innsbruck17:00 - 23:00
MitmachstationFortschritt durch Licht: Wie Treibhausgase nützlich werden!Thema: Naturwissenschaften UmweltDer Klimawandel ist eines der gravierendsten Probleme unserer Gegenwart. Umso wichtiger ist es, Wege zu finden, Treibhausgase wie Kohlenstoffdioxid (CO₂) oder das stärkste bekannte Treibhausgas Schwefelhexafluorid (SF₆) in etwas Nützliches umzuwandeln.Universität Innsbruck17:00 - 23:00 -
 MitmachstationHeilen, Verjüngen, Vorhersagen – Was können Stammzellen und KI heute schon?Thema: Gesundheit NaturwissenschaftenWie können reprogrammierte Stammzellen helfen, Krankheiten wie Parkinson, Alzheimer, Autismus oder Schizophrenie besser zu verstehen – oder sogar zu heilen? Können wir Stammzellen und künstlicher Intelligenz das Gehirn verjüngen oder Organe im Labor züchten? Entdecken Sie die Welt der Stammzellforschung: erleben Sie Mitmachstationen, sprechen Sie mit Forschenden und gewinnen Sie beim Stammzell-Quiz!Universität Innsbruck17:00 - 23:00
MitmachstationHeilen, Verjüngen, Vorhersagen – Was können Stammzellen und KI heute schon?Thema: Gesundheit NaturwissenschaftenWie können reprogrammierte Stammzellen helfen, Krankheiten wie Parkinson, Alzheimer, Autismus oder Schizophrenie besser zu verstehen – oder sogar zu heilen? Können wir Stammzellen und künstlicher Intelligenz das Gehirn verjüngen oder Organe im Labor züchten? Entdecken Sie die Welt der Stammzellforschung: erleben Sie Mitmachstationen, sprechen Sie mit Forschenden und gewinnen Sie beim Stammzell-Quiz!Universität Innsbruck17:00 - 23:00 -
 MitmachstationHygienestation: Bin ich OP-ready? Die wichtigsten VorbereitungsschritteThema: Gesundheit NaturwissenschaftenAn dieser Station üben die Besucher:innen die wichtigsten Vorbereitungsschritte vor einer Operation - vom Anziehen der persönlichen Schutzausrüstung und chirurgischer Händedesinfektion bis zum korrekten Ankleiden.Medizinische Universität Innsbruck17:00 - 23:00
MitmachstationHygienestation: Bin ich OP-ready? Die wichtigsten VorbereitungsschritteThema: Gesundheit NaturwissenschaftenAn dieser Station üben die Besucher:innen die wichtigsten Vorbereitungsschritte vor einer Operation - vom Anziehen der persönlichen Schutzausrüstung und chirurgischer Händedesinfektion bis zum korrekten Ankleiden.Medizinische Universität Innsbruck17:00 - 23:00 -
MitmachstationHygienestation: Wie arbeitet man in einem Pilzlabor und warum ist die Erforschung humanpathogener Pilze wichtig?Thema: Gesundheit NaturwissenschaftenMit Hilfe von Mikroskop und Stereolupe werden verschiedene Pilzarten unter die Lupe genommen. Außerdem klären wir alltägliche Fragen wie: ‚Kann man verschimmeltes Brot noch essen?‘. Eine Pipettierstation gibt es auch.Medizinische Universität Innsbruck17:00 - 23:00
MitmachstationHygienestation: Wie arbeitet man in einem Pilzlabor und warum ist die Erforschung humanpathogener Pilze wichtig?Thema: Gesundheit NaturwissenschaftenMit Hilfe von Mikroskop und Stereolupe werden verschiedene Pilzarten unter die Lupe genommen. Außerdem klären wir alltägliche Fragen wie: ‚Kann man verschimmeltes Brot noch essen?‘. Eine Pipettierstation gibt es auch.Medizinische Universität Innsbruck17:00 - 23:00 -
 MitmachstationHygienestation: Wie vermeiden wir Infektionen?Thema: Gesundheit NaturwissenschaftenKrankheitserreger können über Schmierinfektionen – zum Beispiel durch Hände oder Gegenstände – sowie durch Speicheltröpfchen übertragen werden. Maßnahmen zur richtigen Händehygiene, zur Hygiene im Wohnbereich und zur Vermeidung von Tröpfchenübertragung werden demonstriert und können selbst ausprobiert werden.Medizinische Universität Innsbruck17:00 - 23:00
MitmachstationHygienestation: Wie vermeiden wir Infektionen?Thema: Gesundheit NaturwissenschaftenKrankheitserreger können über Schmierinfektionen – zum Beispiel durch Hände oder Gegenstände – sowie durch Speicheltröpfchen übertragen werden. Maßnahmen zur richtigen Händehygiene, zur Hygiene im Wohnbereich und zur Vermeidung von Tröpfchenübertragung werden demonstriert und können selbst ausprobiert werden.Medizinische Universität Innsbruck17:00 - 23:00 -
 VortragImpfen gegen Krebs - wie geht das?Thema: Gesundheit"Studium Feeling" auch für Kinder. Powerpoint-Präsentation mit gut erfassbaren Cartoons und Grafiken.Medizinische Universität Innsbruck17:00 - 23:00
VortragImpfen gegen Krebs - wie geht das?Thema: Gesundheit"Studium Feeling" auch für Kinder. Powerpoint-Präsentation mit gut erfassbaren Cartoons und Grafiken.Medizinische Universität Innsbruck17:00 - 23:00 -
 AusstellungInformationsstand der Medizinischen Universität InnsbruckThema: GesundheitAn diesem Stand bekommen Sie Informationen zum Standort einzelner Stationen. Wichtig: Platzkarten für Stationen an unseren Kliniken erhalten Sie nur hier! Karten für Eintritte um 17:00 Uhr ab 16:30 Uhr, Karten für spätere Eintritte ab 17:00 Uhr.Medizinische Universität Innsbruck17:00 - 23:00
AusstellungInformationsstand der Medizinischen Universität InnsbruckThema: GesundheitAn diesem Stand bekommen Sie Informationen zum Standort einzelner Stationen. Wichtig: Platzkarten für Stationen an unseren Kliniken erhalten Sie nur hier! Karten für Eintritte um 17:00 Uhr ab 16:30 Uhr, Karten für spätere Eintritte ab 17:00 Uhr.Medizinische Universität Innsbruck17:00 - 23:00 -
 RahmenprogrammInformationsstand der Standortagentur Tirol GmbHThema: WirtschaftAn diesem Stand bekommen Sie Informationen zum Standort einzelner Firmenaussteller und rund um das Thema forschende Tiroler Unternehmen. Im Rahmen der Langen Nacht der Forschung werden rund 30 Firmenaussteller mit 60 Stationen in ganz Tirol betreut. Am Stand im CCB erhalten Sie Informationen zum Tiroler Clusternetzwerk und dem vielfältigen Aufgabenbereich der Standortagentur Tirol.Universität Innsbruck17:00 - 23:00
RahmenprogrammInformationsstand der Standortagentur Tirol GmbHThema: WirtschaftAn diesem Stand bekommen Sie Informationen zum Standort einzelner Firmenaussteller und rund um das Thema forschende Tiroler Unternehmen. Im Rahmen der Langen Nacht der Forschung werden rund 30 Firmenaussteller mit 60 Stationen in ganz Tirol betreut. Am Stand im CCB erhalten Sie Informationen zum Tiroler Clusternetzwerk und dem vielfältigen Aufgabenbereich der Standortagentur Tirol.Universität Innsbruck17:00 - 23:00 -
 RahmenprogrammInformationsstand der Universität InnsbruckThema: Gesundheit NaturwissenschaftenAn diesem Stand bekommen Sie Informationen zum Standort einzelner Stationen. Platzkarten für die Experimentalvorlesung "Wie wird Energie durch chemische Reaktionen entfesselt?" können hier ab 17:00 Uhr abgeholt werden.Universität Innsbruck17:00 - 23:00
RahmenprogrammInformationsstand der Universität InnsbruckThema: Gesundheit NaturwissenschaftenAn diesem Stand bekommen Sie Informationen zum Standort einzelner Stationen. Platzkarten für die Experimentalvorlesung "Wie wird Energie durch chemische Reaktionen entfesselt?" können hier ab 17:00 Uhr abgeholt werden.Universität Innsbruck17:00 - 23:00 -
MitmachstationKannst du die Hormone knacken? Liebe, Körper & Mythen im Escape-RoomThema: Gesundheit NaturwissenschaftenIn einem Escape Room lösen Teams in 20 Minuten verschiedene Rätsel rund um Zyklus, Verhütung, HPV, sexuell übertragbare Infektionen sowie Vielfalt und Identität. Durch interaktive Aufgaben werden medizinische Fakten von Mythen getrennt und Wissen vermittelt, das im Alltag relevant ist: spielerisch, verständlich und ohne Vorwissen.Medizinische Universität Innsbruck17:00 - 23:00
-
 VortragKindervortrag: Geheimcodes in deinem Körper: Was deine Gene über dich verratenNeuThema: GesundheitIn unserem Körper steckt ein geheimer Code: die Gene. In diesem Vortrag entdecken Kinder und Jugendliche, was Gene sind, wie sie von Eltern an Kinder weitergegeben werden und wie sie beeinflussen können, wie wir aussehen oder warum manche Krankheiten entstehen.Medizinische Universität Innsbruck17:00 - 23:00
VortragKindervortrag: Geheimcodes in deinem Körper: Was deine Gene über dich verratenNeuThema: GesundheitIn unserem Körper steckt ein geheimer Code: die Gene. In diesem Vortrag entdecken Kinder und Jugendliche, was Gene sind, wie sie von Eltern an Kinder weitergegeben werden und wie sie beeinflussen können, wie wir aussehen oder warum manche Krankheiten entstehen.Medizinische Universität Innsbruck17:00 - 23:00 -
 MitmachstationNachhaltigkeitsrallye der Tiroler HochschulenThema: UmweltNachhaltigkeit spielerisch entdecken: Die Nachhaltigkeitsrallye der Tiroler Hochschulen führt als digitale Smartphone-Rallye durch verschiedene Stationen der Langen Nacht der Forschung. Mit der App Actionbound werden Quizfragen beantwortet, Aufgaben gelöst und spannende Forschungsprojekte rund um Umwelt, Technologie, Wirtschaft und Gesellschaft erkundet. Attraktive Preise warten auf erfolgreiche Teilnehmende.Medizinische Universität Innsbruck17:00 - 23:00
MitmachstationNachhaltigkeitsrallye der Tiroler HochschulenThema: UmweltNachhaltigkeit spielerisch entdecken: Die Nachhaltigkeitsrallye der Tiroler Hochschulen führt als digitale Smartphone-Rallye durch verschiedene Stationen der Langen Nacht der Forschung. Mit der App Actionbound werden Quizfragen beantwortet, Aufgaben gelöst und spannende Forschungsprojekte rund um Umwelt, Technologie, Wirtschaft und Gesellschaft erkundet. Attraktive Preise warten auf erfolgreiche Teilnehmende.Medizinische Universität Innsbruck17:00 - 23:00 -
 WorkshopPlastische Chirurgie: Angeborene Fehlbildungen - Welche plastisch-chirurgischen Behandlungsmöglichkeiten gibt es?Thema: Gesundheit NaturwissenschaftenAnhand eines Workshops mit Vortrag werden Informationen vermittelt zu: Was sind die häufigsten angeborenen Fehlbildungen? Wann besteht eine Operationsindikation? Welche plastisch-chirurgischen Korrekturmöglichkeiten gibt es? Wie sieht die Nachbehandlung aus? In einer Demonstration erhalten Sie einen Überblick über Operations- und Nachbehandlungsmethoden.Medizinische Universität Innsbruck17:00 - 23:00
WorkshopPlastische Chirurgie: Angeborene Fehlbildungen - Welche plastisch-chirurgischen Behandlungsmöglichkeiten gibt es?Thema: Gesundheit NaturwissenschaftenAnhand eines Workshops mit Vortrag werden Informationen vermittelt zu: Was sind die häufigsten angeborenen Fehlbildungen? Wann besteht eine Operationsindikation? Welche plastisch-chirurgischen Korrekturmöglichkeiten gibt es? Wie sieht die Nachbehandlung aus? In einer Demonstration erhalten Sie einen Überblick über Operations- und Nachbehandlungsmethoden.Medizinische Universität Innsbruck17:00 - 23:00 -
 VortragPlastische Chirurgie: Faszination Hand - ein Geniestreich der Natur: Was macht die Handchirurgie?Thema: GesundheitDie Funktion unserer Hände ist ein evolutionärer Geniestreich, der uns im Alltag oft unbewusst viele bemerkenswerte Fähigkeiten ermöglicht. Doch was, wenn unsere Hände verletzt sind? In diesem Vortrag werden über die vielfältigen Anwendungsfelder der Handchirurgie informiert.Medizinische Universität Innsbruck17:00 - 23:00
VortragPlastische Chirurgie: Faszination Hand - ein Geniestreich der Natur: Was macht die Handchirurgie?Thema: GesundheitDie Funktion unserer Hände ist ein evolutionärer Geniestreich, der uns im Alltag oft unbewusst viele bemerkenswerte Fähigkeiten ermöglicht. Doch was, wenn unsere Hände verletzt sind? In diesem Vortrag werden über die vielfältigen Anwendungsfelder der Handchirurgie informiert.Medizinische Universität Innsbruck17:00 - 23:00 -
 VortragPlastische Chirurgie: Funktion, Form und SchönheitThema: GesundheitIn diesem Vortrag werden die Behandlungsmöglichkeiten der plastischen Chirurgie im Bereich der rekonstruktiven Chirurgie vorgestellt.Medizinische Universität Innsbruck17:00 - 23:00
VortragPlastische Chirurgie: Funktion, Form und SchönheitThema: GesundheitIn diesem Vortrag werden die Behandlungsmöglichkeiten der plastischen Chirurgie im Bereich der rekonstruktiven Chirurgie vorgestellt.Medizinische Universität Innsbruck17:00 - 23:00 -
 WorkshopPlastische Chirurgie: Kann Fett auch nützlich sein? - Warum eine Fettabsaugung nicht immer eine Schönheitsoperation ist!Thema: GesundheitIn diesem Workshop wird Wissenswertes über unser Fettgewebe und seine klinischen Anwendungsmöglichkeiten vermittelt! Klinische Geräte zur Fettabsaugung stehen bereit, während humane Fettstammzellen und ex vivo kultiviertes Fettgewebe unter dem Labormikroskop betrachtet werden können.Medizinische Universität Innsbruck17:00 - 23:00
WorkshopPlastische Chirurgie: Kann Fett auch nützlich sein? - Warum eine Fettabsaugung nicht immer eine Schönheitsoperation ist!Thema: GesundheitIn diesem Workshop wird Wissenswertes über unser Fettgewebe und seine klinischen Anwendungsmöglichkeiten vermittelt! Klinische Geräte zur Fettabsaugung stehen bereit, während humane Fettstammzellen und ex vivo kultiviertes Fettgewebe unter dem Labormikroskop betrachtet werden können.Medizinische Universität Innsbruck17:00 - 23:00 -
 MitmachstationPlastische Chirurgie: Plastisch-Rekonstruktive Chirurgie im GesichtThema: Gesundheit NaturwissenschaftenNach Unfällen, Verbrennungen oder der operativen Entfernung von Tumoren im Gesicht können funktionelle und psychische Probleme entstehen. Die Station zeigt, welche Möglichkeiten die Plastische Chirurgie bietet, um fehlende oder beschädigte Teile von Nase oder Ohr wiederherzustellen.Medizinische Universität Innsbruck17:00 - 23:00
MitmachstationPlastische Chirurgie: Plastisch-Rekonstruktive Chirurgie im GesichtThema: Gesundheit NaturwissenschaftenNach Unfällen, Verbrennungen oder der operativen Entfernung von Tumoren im Gesicht können funktionelle und psychische Probleme entstehen. Die Station zeigt, welche Möglichkeiten die Plastische Chirurgie bietet, um fehlende oder beschädigte Teile von Nase oder Ohr wiederherzustellen.Medizinische Universität Innsbruck17:00 - 23:00 -
 MitmachstationPlastische Chirurgie: Schnappt der Finger - oder was kann ich für Sie tun? Geht Ihnen was auf die Nerven?Thema: Gesundheit NaturwissenschaftenDie verschiedensten Bereiche der Behandlung an den Händen und den Nerven, bedingt durch angeborene oder erworbene Veränderungen oder Verletzungen inkl. der Hand(ergo-)therapie werden dargestellt.Medizinische Universität Innsbruck17:00 - 23:00
MitmachstationPlastische Chirurgie: Schnappt der Finger - oder was kann ich für Sie tun? Geht Ihnen was auf die Nerven?Thema: Gesundheit NaturwissenschaftenDie verschiedensten Bereiche der Behandlung an den Händen und den Nerven, bedingt durch angeborene oder erworbene Veränderungen oder Verletzungen inkl. der Hand(ergo-)therapie werden dargestellt.Medizinische Universität Innsbruck17:00 - 23:00 -
 MitmachstationPlastische Chirurgie: Trends in der ästhetischen und rekonstruktiven Brustchirurgie: Welche Möglichkeiten bietet Plastische Chirurgie?Thema: GesundheitDie Teilnehmer:innen erforschen die Haptik und Funktion von Brustimplantaten und Expandern (auffüllbare Silikonimplantate) und untersuchen verschiedene Texturen und Füllungen. Ein mikroskopischer Blick zeigt, wie Implantatoberflächen die Interaktion von Zellen und Bakterien beeinflussen. In Vorträgen geht es um Brustkrebsdiagnose und -rekonstruktion, Brustverkleinerung und die Risiken von Brustimplantaten.Medizinische Universität Innsbruck17:00 - 23:00
MitmachstationPlastische Chirurgie: Trends in der ästhetischen und rekonstruktiven Brustchirurgie: Welche Möglichkeiten bietet Plastische Chirurgie?Thema: GesundheitDie Teilnehmer:innen erforschen die Haptik und Funktion von Brustimplantaten und Expandern (auffüllbare Silikonimplantate) und untersuchen verschiedene Texturen und Füllungen. Ein mikroskopischer Blick zeigt, wie Implantatoberflächen die Interaktion von Zellen und Bakterien beeinflussen. In Vorträgen geht es um Brustkrebsdiagnose und -rekonstruktion, Brustverkleinerung und die Risiken von Brustimplantaten.Medizinische Universität Innsbruck17:00 - 23:00 -
 MitmachstationPlastische Chirurgie: Was ist Plastische Chirurgie?Thema: Gesundheit NaturwissenschaftenPlastische Chirurgie ist viel mehr als Schönheitschirurgie. Gerne zeigen wir Ihnen die verschiedensten Bereiche der Plastischen Chirurgie mit Behandlungen von Verbrennungen, Wiederherstellung nach Trauma, Tumor oder Fehlbildung. Die Wiederherstellung mit Eigengewebe steht ganz im Vordergrund. Von Kopf bis Fuß - von jung bis alt.Medizinische Universität Innsbruck17:00 - 23:00
MitmachstationPlastische Chirurgie: Was ist Plastische Chirurgie?Thema: Gesundheit NaturwissenschaftenPlastische Chirurgie ist viel mehr als Schönheitschirurgie. Gerne zeigen wir Ihnen die verschiedensten Bereiche der Plastischen Chirurgie mit Behandlungen von Verbrennungen, Wiederherstellung nach Trauma, Tumor oder Fehlbildung. Die Wiederherstellung mit Eigengewebe steht ganz im Vordergrund. Von Kopf bis Fuß - von jung bis alt.Medizinische Universität Innsbruck17:00 - 23:00 -
 VortragPlastische Chirurgie: Wenn Skalpell auf Spielkonsole trifft – wie verändern Mixed Reality und Smart Games die Plastische Chirurgie?Thema: Gesundheit NaturwissenschaftenBei dieser Station zeigen wir, wie moderne Technologien die Plastische Chirurgie verändern.Medizinische Universität Innsbruck17:00 - 23:00
VortragPlastische Chirurgie: Wenn Skalpell auf Spielkonsole trifft – wie verändern Mixed Reality und Smart Games die Plastische Chirurgie?Thema: Gesundheit NaturwissenschaftenBei dieser Station zeigen wir, wie moderne Technologien die Plastische Chirurgie verändern.Medizinische Universität Innsbruck17:00 - 23:00 -
 VortragPlastische Chirurgie: Wenn eine große Brust zur Belastung wird - Welche Behandlungsmöglichkeiten gibt es?Thema: GesundheitIn diesem Vortrag werden Sie über die Kriterien, welche erfüllt werden müssen, um eine Brustverkleinerung auf Krankenkassenbasis zu bekommen, informiert. Zudem wird Ihnen die Operationstechnik und das Vorgehen nach der Operation veranschaulicht. Im Nachgang an den Vortrag, beantworten wir Ihnen gerne alle Fragen, die Sie beschäftigen.Medizinische Universität Innsbruck17:00 - 23:00
VortragPlastische Chirurgie: Wenn eine große Brust zur Belastung wird - Welche Behandlungsmöglichkeiten gibt es?Thema: GesundheitIn diesem Vortrag werden Sie über die Kriterien, welche erfüllt werden müssen, um eine Brustverkleinerung auf Krankenkassenbasis zu bekommen, informiert. Zudem wird Ihnen die Operationstechnik und das Vorgehen nach der Operation veranschaulicht. Im Nachgang an den Vortrag, beantworten wir Ihnen gerne alle Fragen, die Sie beschäftigen.Medizinische Universität Innsbruck17:00 - 23:00 -
 MitmachstationPlastische Chirurgie: Wie sieht ein Operationssaal aus? Was kann ich dort mit einem Operationsmikroskop machen?Thema: GesundheitWir präsentieren ein Operationssaal und ein Operationsmikroskop. Wie sieht ein Operationssaal aus? Welche Hygienevorschriften müssen eingehalten werden? Was kann man mit einem Operationsmikroskop machen? Während einer spannenden Führung erhalten die Teilnehmer:innen Einblick in einen Operationssaal sowie die Möglichkeit an einem Operationsmikroskop unter 6- bis 25-facher Vergrößerung einzelne Nähte zu üben.Medizinische Universität Innsbruck17:00 - 23:00
MitmachstationPlastische Chirurgie: Wie sieht ein Operationssaal aus? Was kann ich dort mit einem Operationsmikroskop machen?Thema: GesundheitWir präsentieren ein Operationssaal und ein Operationsmikroskop. Wie sieht ein Operationssaal aus? Welche Hygienevorschriften müssen eingehalten werden? Was kann man mit einem Operationsmikroskop machen? Während einer spannenden Führung erhalten die Teilnehmer:innen Einblick in einen Operationssaal sowie die Möglichkeit an einem Operationsmikroskop unter 6- bis 25-facher Vergrößerung einzelne Nähte zu üben.Medizinische Universität Innsbruck17:00 - 23:00 -
 MitmachstationPlastische Chirurgie: Zu heiß erwischt? – Was ist jetzt bei Verbrennungen und Verätzungen zu tun?Thema: GesundheitVortrag, Posterpräsentation und interaktive Mitmachstation zum Thema Verbrennungen und Verätzungen. Besucher:innen lernen die Schweregrade kennen, üben Erste-Hilfe-Maßnahmen und erfahren, wann eine klinische Behandlung notwendig ist.Medizinische Universität Innsbruck17:00 - 23:00
MitmachstationPlastische Chirurgie: Zu heiß erwischt? – Was ist jetzt bei Verbrennungen und Verätzungen zu tun?Thema: GesundheitVortrag, Posterpräsentation und interaktive Mitmachstation zum Thema Verbrennungen und Verätzungen. Besucher:innen lernen die Schweregrade kennen, üben Erste-Hilfe-Maßnahmen und erfahren, wann eine klinische Behandlung notwendig ist.Medizinische Universität Innsbruck17:00 - 23:00 -
 MitmachstationRätsel der Nacht – Warum manche im Dunkeln nichts sehen könnenThema: Digitalisierung GesundheitAbends den Türgriff nicht finden – Alltag mit angeborener Nachtblindheit. Ursache: eine Mutation im Kalziumkanal stört Netzhautzellen. Lernen Sie die Netzhaut kennen, vergleichen Sie gesunde und defekte Zellen und erleben Sie mit VR-Brillen die Perspektive Betroffener. Entdecken Sie, wie Forschung an winzigen Molekülen arbeitet, um seltene Erkrankungen zu verstehen!Universität Innsbruck17:00 - 23:00
MitmachstationRätsel der Nacht – Warum manche im Dunkeln nichts sehen könnenThema: Digitalisierung GesundheitAbends den Türgriff nicht finden – Alltag mit angeborener Nachtblindheit. Ursache: eine Mutation im Kalziumkanal stört Netzhautzellen. Lernen Sie die Netzhaut kennen, vergleichen Sie gesunde und defekte Zellen und erleben Sie mit VR-Brillen die Perspektive Betroffener. Entdecken Sie, wie Forschung an winzigen Molekülen arbeitet, um seltene Erkrankungen zu verstehen!Universität Innsbruck17:00 - 23:00 -
 Experiment / VorführungSandoz: Wie sieht die faszinierende Welt der Arzneimittelproduktion aus? Welche Eigenschaften von Wirkstoffen entfalten sich in der Magie der Kristalle?Thema: Naturwissenschaften TechnikVom Wirkstoff zur Tablette: Bei Station 1 betrachtet man unterschiedliche Kristallformen von Wirkstoffen - die Magie der Kristalle. Station 2 zeigt diverse Hilfsstoffe und ihre Eigenschaften, die für die Produktion von Tabletten relevant sind. An Station 3 zeigen wir zwei unterschiedliche Technologien für die Tablettenherstellung, die klassische Verpressung und das Prinzip der Tablettenherstellung mittels 3D Druck.Sandoz GmbH17:00 - 23:00
Experiment / VorführungSandoz: Wie sieht die faszinierende Welt der Arzneimittelproduktion aus? Welche Eigenschaften von Wirkstoffen entfalten sich in der Magie der Kristalle?Thema: Naturwissenschaften TechnikVom Wirkstoff zur Tablette: Bei Station 1 betrachtet man unterschiedliche Kristallformen von Wirkstoffen - die Magie der Kristalle. Station 2 zeigt diverse Hilfsstoffe und ihre Eigenschaften, die für die Produktion von Tabletten relevant sind. An Station 3 zeigen wir zwei unterschiedliche Technologien für die Tablettenherstellung, die klassische Verpressung und das Prinzip der Tablettenherstellung mittels 3D Druck.Sandoz GmbH17:00 - 23:00 -
 MitmachstationSinnvoll forschen: Naturstoffe erleben - Verborgenes Leben in der FichteThema: Gesundheit UmweltIn der Gemeinen Fichte (Picea abies) leben winzige Mikroorganismen – sogenannte Endophyten –, die unter anderem den Baum vor Krankheitserregern schützen. Besucherinnen und Besucher können junge Fichtensämlinge entdecken, Mikroben aus Fichtennadeln betrachten und erfahren, wie diese verborgenen Helfer zur Gesundheit des Waldes beitragen.Universität Innsbruck17:00 - 23:00
MitmachstationSinnvoll forschen: Naturstoffe erleben - Verborgenes Leben in der FichteThema: Gesundheit UmweltIn der Gemeinen Fichte (Picea abies) leben winzige Mikroorganismen – sogenannte Endophyten –, die unter anderem den Baum vor Krankheitserregern schützen. Besucherinnen und Besucher können junge Fichtensämlinge entdecken, Mikroben aus Fichtennadeln betrachten und erfahren, wie diese verborgenen Helfer zur Gesundheit des Waldes beitragen.Universität Innsbruck17:00 - 23:00 -
 MitmachstationSinnvoll forschen: Naturstoffe erleben - ChromatographieThema: Gesundheit UmweltChromatographie hilft uns, die Geheimnisse von Pflanzen zu entdecken. An unserer Station können Kinder mit Filzstiften farbige Punkte auf Papier setzen und erleben, wie sich die Farben im Wasser trennen und wunderschöne Filterpapier-Blumen entstehen. Danach gibt es ein Foto in Labormantel in unserer Forscher-Fotobox. Ein tolles Andenken für kleine Wissenschaftlerinnen und Wissenschaftler.Universität Innsbruck17:00 - 23:00
MitmachstationSinnvoll forschen: Naturstoffe erleben - ChromatographieThema: Gesundheit UmweltChromatographie hilft uns, die Geheimnisse von Pflanzen zu entdecken. An unserer Station können Kinder mit Filzstiften farbige Punkte auf Papier setzen und erleben, wie sich die Farben im Wasser trennen und wunderschöne Filterpapier-Blumen entstehen. Danach gibt es ein Foto in Labormantel in unserer Forscher-Fotobox. Ein tolles Andenken für kleine Wissenschaftlerinnen und Wissenschaftler.Universität Innsbruck17:00 - 23:00 -
 AusstellungSinnvoll forschen: Naturstoffe erleben - HaselfichteThema: Gesundheit NaturwissenschaftenDie Haselfichte ist eine seltene Wuchsform der Fichte, die vor allem in alpinen Wäldern vorkommt. Ihr Holz wird wegen seiner besonderen Klangeigenschaften seit Jahrhunderten im Instrumentenbau verwendet. Unsere Station zeigt, wie man Haselfichten erkennt, erläutert ihre einzigartigen Holzeigenschaften und gibt Einblick in aktuelle Forschungsansätze zu ihrer noch ungeklärten Entstehung.Universität Innsbruck17:00 - 23:00
AusstellungSinnvoll forschen: Naturstoffe erleben - HaselfichteThema: Gesundheit NaturwissenschaftenDie Haselfichte ist eine seltene Wuchsform der Fichte, die vor allem in alpinen Wäldern vorkommt. Ihr Holz wird wegen seiner besonderen Klangeigenschaften seit Jahrhunderten im Instrumentenbau verwendet. Unsere Station zeigt, wie man Haselfichten erkennt, erläutert ihre einzigartigen Holzeigenschaften und gibt Einblick in aktuelle Forschungsansätze zu ihrer noch ungeklärten Entstehung.Universität Innsbruck17:00 - 23:00 -
 AusstellungSinnvoll forschen: Naturstoffe erleben - HonAIThema: Gesundheit NaturwissenschaftenHonig ist weit mehr als ein süßer Brotaufstrich. Das Produkt der Europäischen Honigbiene enthält Wasser, Zucker, Proteine und Verbindungen pflanzlichen Ursprungs, die während seiner Entstehung in den Honig gelangen. Unsere Station zeigt die Vielfalt des Tiroler Honigs, erklärt zentrale Qualitätsparameter und beleuchtet seine antioxidativen, antientzündlichen und antimikrobiellen Eigenschaften.Universität Innsbruck17:00 - 23:00
AusstellungSinnvoll forschen: Naturstoffe erleben - HonAIThema: Gesundheit NaturwissenschaftenHonig ist weit mehr als ein süßer Brotaufstrich. Das Produkt der Europäischen Honigbiene enthält Wasser, Zucker, Proteine und Verbindungen pflanzlichen Ursprungs, die während seiner Entstehung in den Honig gelangen. Unsere Station zeigt die Vielfalt des Tiroler Honigs, erklärt zentrale Qualitätsparameter und beleuchtet seine antioxidativen, antientzündlichen und antimikrobiellen Eigenschaften.Universität Innsbruck17:00 - 23:00 -
 MitmachstationSinnvoll forschen: Naturstoffe erleben - Ätherische ÖleThema: Gesundheit UmweltÄtherische Öle stecken in vielen Heilpflanzen und helfen zum Beispiel bei Erkältungen. An unserer Station können Kinder und Erwachsene versuchen ätherische Öle, die aus der Küche bekannt sind anhand des Geruchs zu erkennen. Wer richtig liegt, kann kleine Preise gewinnen. Ein duftendes Abenteuer für Groß und KleinUniversität Innsbruck17:00 - 23:00
MitmachstationSinnvoll forschen: Naturstoffe erleben - Ätherische ÖleThema: Gesundheit UmweltÄtherische Öle stecken in vielen Heilpflanzen und helfen zum Beispiel bei Erkältungen. An unserer Station können Kinder und Erwachsene versuchen ätherische Öle, die aus der Küche bekannt sind anhand des Geruchs zu erkennen. Wer richtig liegt, kann kleine Preise gewinnen. Ein duftendes Abenteuer für Groß und KleinUniversität Innsbruck17:00 - 23:00 -
 MitmachstationTransplantArt. Die Kunst der Organtransplantation: Kunst aus Pipetten?Thema: GesundheitMit Pipetten werden in der Forschung Flüssigkeiten transportiert. Wieso nicht auch Farbe? Kinder können hier mit Pipetten ihre eigenen Kunstwerke kreieren.Medizinische Universität Innsbruck17:00 - 23:00
MitmachstationTransplantArt. Die Kunst der Organtransplantation: Kunst aus Pipetten?Thema: GesundheitMit Pipetten werden in der Forschung Flüssigkeiten transportiert. Wieso nicht auch Farbe? Kinder können hier mit Pipetten ihre eigenen Kunstwerke kreieren.Medizinische Universität Innsbruck17:00 - 23:00 -
 MitmachstationTransplantArt. Die Kunst der Organtransplantation: Wie funktioniert Supercooling?Thema: GesundheitSupercooling ist eine neue Methode, um Organe länger und eisfrei zu konservieren. Aber wie funktioniert das? An dieser Station stellen wir einen Supercooler und seine Funktion vor.Medizinische Universität Innsbruck17:00 - 23:00
MitmachstationTransplantArt. Die Kunst der Organtransplantation: Wie funktioniert Supercooling?Thema: GesundheitSupercooling ist eine neue Methode, um Organe länger und eisfrei zu konservieren. Aber wie funktioniert das? An dieser Station stellen wir einen Supercooler und seine Funktion vor.Medizinische Universität Innsbruck17:00 - 23:00 -
 MitmachstationTransplantArt. Die Kunst der Organtransplantation: Wie funktioniert die Perfusionsmaschine "Metra"?Thema: GesundheitMaschinelle Organperfusion versorgt Organe außerhalb des Körpers mit nährstoffreichem Blut, um das Organleben zu verlängern. Wir zeigen anhand der Perfusionsmaschine "Metra", wie das System funktioniert.Medizinische Universität Innsbruck17:00 - 23:00
MitmachstationTransplantArt. Die Kunst der Organtransplantation: Wie funktioniert die Perfusionsmaschine "Metra"?Thema: GesundheitMaschinelle Organperfusion versorgt Organe außerhalb des Körpers mit nährstoffreichem Blut, um das Organleben zu verlängern. Wir zeigen anhand der Perfusionsmaschine "Metra", wie das System funktioniert.Medizinische Universität Innsbruck17:00 - 23:00 -
 MitmachstationTransplantArt. Die Kunst der Organtransplantation: Wie näht man Blutgefäße zusammen?Thema: GesundheitDie Naht ist eine Grundlage chirurgischer Fähigkeiten. Besucher:innen sind eingeladen, sich selbst mithilfe eines Operationsmikroskops an einer Naht zu versuchen.Medizinische Universität Innsbruck17:00 - 23:00
MitmachstationTransplantArt. Die Kunst der Organtransplantation: Wie näht man Blutgefäße zusammen?Thema: GesundheitDie Naht ist eine Grundlage chirurgischer Fähigkeiten. Besucher:innen sind eingeladen, sich selbst mithilfe eines Operationsmikroskops an einer Naht zu versuchen.Medizinische Universität Innsbruck17:00 - 23:00 -
 MitmachstationTransplantArt. Die Kunst der Organtransplantation: Wie sieht der Mensch von innen aus?Thema: GesundheitWie sieht ein Mensch eigentlich von innen aus? Welche Organe haben wir und wofür brauchen wir sie? Kinder können auf spielerische Art und Weise mehr über die Organe des Menschen erfahren.Medizinische Universität Innsbruck17:00 - 23:00
MitmachstationTransplantArt. Die Kunst der Organtransplantation: Wie sieht der Mensch von innen aus?Thema: GesundheitWie sieht ein Mensch eigentlich von innen aus? Welche Organe haben wir und wofür brauchen wir sie? Kinder können auf spielerische Art und Weise mehr über die Organe des Menschen erfahren.Medizinische Universität Innsbruck17:00 - 23:00 -
 MitmachstationTransplantArt. Die Kunst der Organtransplantation: Wie viele Zellen zählst du?Thema: GesundheitWer erreicht den Highscore? Testet Eure Konzentrationsfähigkeit bei einem Zellenzählspiel!Medizinische Universität Innsbruck17:00 - 23:00
MitmachstationTransplantArt. Die Kunst der Organtransplantation: Wie viele Zellen zählst du?Thema: GesundheitWer erreicht den Highscore? Testet Eure Konzentrationsfähigkeit bei einem Zellenzählspiel!Medizinische Universität Innsbruck17:00 - 23:00 -
 MitmachstationVira Therapeutics: Was haben Viren und Superhelden gemeinsam?Thema: Gesundheit NaturwissenschaftenLernt interaktiv die Welt der Viren und das sichere Arbeiten im Labor kennen. Bekommt einen Einblick, wie wir im Labor Viren trainieren um ihnen therapeutische Superkräfte zu verleihen. Entdeckt mehr über den Prozess der Viren-Herstellung - eine Wissenschaft für sich. Kommt bei unserem Stand vorbei! Dort warten ein Mini-Buch, Spiele und Informationen zu unserem Arbeitsalltag sowie zur Labor-Sicherheit auf euch.ViraTherapeutics GmbH17:00 - 22:30
MitmachstationVira Therapeutics: Was haben Viren und Superhelden gemeinsam?Thema: Gesundheit NaturwissenschaftenLernt interaktiv die Welt der Viren und das sichere Arbeiten im Labor kennen. Bekommt einen Einblick, wie wir im Labor Viren trainieren um ihnen therapeutische Superkräfte zu verleihen. Entdeckt mehr über den Prozess der Viren-Herstellung - eine Wissenschaft für sich. Kommt bei unserem Stand vorbei! Dort warten ein Mini-Buch, Spiele und Informationen zu unserem Arbeitsalltag sowie zur Labor-Sicherheit auf euch.ViraTherapeutics GmbH17:00 - 22:30 -
 VortragWarum ist gleich nicht immer gleich? Gender und Diversität in der MedizinThema: GesundheitEs erwarten Sie interaktive Vorträge. Die Inhalte sind verständlich aufbereitet und in einfacher Sprache erklärt, sodass keine medizinischen Vorkenntnisse erforderlich sind. Die Vorträge richten sich an ein breites Publikum.Medizinische Universität Innsbruck17:00 - 23:00
VortragWarum ist gleich nicht immer gleich? Gender und Diversität in der MedizinThema: GesundheitEs erwarten Sie interaktive Vorträge. Die Inhalte sind verständlich aufbereitet und in einfacher Sprache erklärt, sodass keine medizinischen Vorkenntnisse erforderlich sind. Die Vorträge richten sich an ein breites Publikum.Medizinische Universität Innsbruck17:00 - 23:00 -
 MitmachstationWarum ist psychische Gesundheit rund um die Geburt ein Thema, das uns alle angeht?Thema: Gesundheit NaturwissenschaftenUnsere Station ist als interaktive Mitmach- und Dialogstation gestaltet. Besucher:innen können über spielerische Aktivitäten für Kinder, kurze Wissensimpulse für Erwachsene sowie kleine Forumstheater-Sequenzen entdecken, wie sich psychische Gesundheit rund um die Schwangerschaft und Geburt zeigt und warum Aufklärung und Entstigmatisierung so wichtig sind.Medizinische Universität Innsbruck17:00 - 23:00
MitmachstationWarum ist psychische Gesundheit rund um die Geburt ein Thema, das uns alle angeht?Thema: Gesundheit NaturwissenschaftenUnsere Station ist als interaktive Mitmach- und Dialogstation gestaltet. Besucher:innen können über spielerische Aktivitäten für Kinder, kurze Wissensimpulse für Erwachsene sowie kleine Forumstheater-Sequenzen entdecken, wie sich psychische Gesundheit rund um die Schwangerschaft und Geburt zeigt und warum Aufklärung und Entstigmatisierung so wichtig sind.Medizinische Universität Innsbruck17:00 - 23:00 -
 FührungWas gibt es Neues in der Schlaganfallbehandlung?Thema: GesundheitEinführungsvortrag, Führung im Krankenhaus: Computertomographie und moderne Rehabilitation.Medizinische Universität Innsbruck17:00 - 18:00
FührungWas gibt es Neues in der Schlaganfallbehandlung?Thema: GesundheitEinführungsvortrag, Führung im Krankenhaus: Computertomographie und moderne Rehabilitation.Medizinische Universität Innsbruck17:00 - 18:00 -
 MitmachstationWas haben eine Zelle und eine Stadt gemeinsam?Thema: GesundheitStau auf Aktinfilamenten? Entdecke die Bestandteile von Zellen mittels Fluoreszenzmikroskopen und lerne über deren Aufgaben.Medizinische Universität Innsbruck17:00 - 23:00
MitmachstationWas haben eine Zelle und eine Stadt gemeinsam?Thema: GesundheitStau auf Aktinfilamenten? Entdecke die Bestandteile von Zellen mittels Fluoreszenzmikroskopen und lerne über deren Aufgaben.Medizinische Universität Innsbruck17:00 - 23:00 -
 MitmachstationWas ist "bunt"? - Die Welt der Effektpigmente und StrukturfarbenThema: Naturwissenschaften TechnikWieso ist ein Schmetterling bunt? Wie funktionieren Thermotassen? Diesen und weiteren spannenden Fragen rund um die Themen Lacke, Pigmente und Strukturfarben gehen wir an unserer Station auf den Grund. Wir stellen unseren eigenen Lack her, untersuchen Flügel von Schmetterlingen und schauen uns an, wo uns die Themen "Farbe" und "Beschichtungen" in der Forschung begegnen.Universität Innsbruck17:00 - 23:00
MitmachstationWas ist "bunt"? - Die Welt der Effektpigmente und StrukturfarbenThema: Naturwissenschaften TechnikWieso ist ein Schmetterling bunt? Wie funktionieren Thermotassen? Diesen und weiteren spannenden Fragen rund um die Themen Lacke, Pigmente und Strukturfarben gehen wir an unserer Station auf den Grund. Wir stellen unseren eigenen Lack her, untersuchen Flügel von Schmetterlingen und schauen uns an, wo uns die Themen "Farbe" und "Beschichtungen" in der Forschung begegnen.Universität Innsbruck17:00 - 23:00 -
 MitmachstationWas verrät dein Atem über dich?Thema: Gesundheit NaturwissenschaftenAn unserer Mitmachstation demonstrieren wir, wie präzise geringste Mengen flüchtiger Verbindungen in der Atemluft detektiert werden können. Besucher sind herzlich eingeladen, ihre Atemluft analysieren zu lassen.Universität Innsbruck17:00 - 23:00
MitmachstationWas verrät dein Atem über dich?Thema: Gesundheit NaturwissenschaftenAn unserer Mitmachstation demonstrieren wir, wie präzise geringste Mengen flüchtiger Verbindungen in der Atemluft detektiert werden können. Besucher sind herzlich eingeladen, ihre Atemluft analysieren zu lassen.Universität Innsbruck17:00 - 23:00 -
 WorkshopWas verrät uns unser Gehirn? Einblick in die Arbeit der NeuropathologieThema: GesundheitIn diesem Workshop untersuchen wir gemeinsam ein menschliches Gehirn und erklären anschaulich dessen Aufbau. Dabei gewinnen wir Einblicke in die Anatomie und Funktion, und erfahren, wie sich neurologische Erkrankungen im Gewebe widerspiegeln.Medizinische Universität Innsbruck17:00 - 23:00
WorkshopWas verrät uns unser Gehirn? Einblick in die Arbeit der NeuropathologieThema: GesundheitIn diesem Workshop untersuchen wir gemeinsam ein menschliches Gehirn und erklären anschaulich dessen Aufbau. Dabei gewinnen wir Einblicke in die Anatomie und Funktion, und erfahren, wie sich neurologische Erkrankungen im Gewebe widerspiegeln.Medizinische Universität Innsbruck17:00 - 23:00 -
 MitmachstationWelche Bedeutung haben Kristalle in Medikamenten?Thema: Gesundheit NaturwissenschaftenDie meisten Arzneistoffe werden in kristalliner Form zu Medikamenten/Tabletten verarbeitet – aber warum eigentlich? Und wie beeinflussen die Eigenschaften dieser Kristalle die Wirksamkeit nach der Einnahme? Erfahren Sie, warum die Kristallformen die Qualität eines Medikaments bestimmen und entdecken Sie die verborgene ästhetische Welt von Arzneistoffkristallen mit dem Polarisationsmikroskop.Universität Innsbruck17:00 - 23:00
MitmachstationWelche Bedeutung haben Kristalle in Medikamenten?Thema: Gesundheit NaturwissenschaftenDie meisten Arzneistoffe werden in kristalliner Form zu Medikamenten/Tabletten verarbeitet – aber warum eigentlich? Und wie beeinflussen die Eigenschaften dieser Kristalle die Wirksamkeit nach der Einnahme? Erfahren Sie, warum die Kristallformen die Qualität eines Medikaments bestimmen und entdecken Sie die verborgene ästhetische Welt von Arzneistoffkristallen mit dem Polarisationsmikroskop.Universität Innsbruck17:00 - 23:00 -
 MitmachstationWer hat die besseren kognitiven Fähigkeiten? Kinder oder Erwachsene?Thema: Gesundheit NaturwissenschaftenWir erklären, welche kognitiven Fähigkeiten (Sprache, Gedächtnis, Aufmerksamkeit, Verarbeitungsgeschwindigkeit, kognitive Kontrolle etc.) es gibt, wie diese zusammenhängen und wie sie im Gehirn verankert sind. Außerdem gibt es die Möglichkeit für Kinder und Erwachsene, ihre unterschiedlichen kognitiven Funktionen selbst unter Beweis zu stellen.Medizinische Universität Innsbruck17:00 - 23:00
MitmachstationWer hat die besseren kognitiven Fähigkeiten? Kinder oder Erwachsene?Thema: Gesundheit NaturwissenschaftenWir erklären, welche kognitiven Fähigkeiten (Sprache, Gedächtnis, Aufmerksamkeit, Verarbeitungsgeschwindigkeit, kognitive Kontrolle etc.) es gibt, wie diese zusammenhängen und wie sie im Gehirn verankert sind. Außerdem gibt es die Möglichkeit für Kinder und Erwachsene, ihre unterschiedlichen kognitiven Funktionen selbst unter Beweis zu stellen.Medizinische Universität Innsbruck17:00 - 23:00 -
 MitmachstationWie bauen wir ein Protein? Die Biochemie des Lebens von der DNA zum ProteinThema: Gesundheit NaturwissenschaftenDNA, RNA, Proteine: was ist das eigentlich und wie hängen diese Begriffe zusammen? Bei uns erlernen Sie experimentell und im Workshop den biochemischen Fluss des Lebens. Am Institut für Biochemie erforschen wir wie biochemische Prozesse in Stoffwechselprozessen und -erkrankungen und Krebs involviert sind. Anhand verschiedener Poster führen wir Sie durch unsere aktuelle Forschung.Universität Innsbruck17:00 - 23:00
MitmachstationWie bauen wir ein Protein? Die Biochemie des Lebens von der DNA zum ProteinThema: Gesundheit NaturwissenschaftenDNA, RNA, Proteine: was ist das eigentlich und wie hängen diese Begriffe zusammen? Bei uns erlernen Sie experimentell und im Workshop den biochemischen Fluss des Lebens. Am Institut für Biochemie erforschen wir wie biochemische Prozesse in Stoffwechselprozessen und -erkrankungen und Krebs involviert sind. Anhand verschiedener Poster führen wir Sie durch unsere aktuelle Forschung.Universität Innsbruck17:00 - 23:00 -
 MitmachstationWie entschlüsselt man DNA - kannst du das auch mit Lego?Thema: Gesundheit NaturwissenschaftenAn dieser interaktiven Station kannst du selbst aus Lego DNA bauen und mit einem Lego-Roboter spielerisch auslesen - schaffst du es Sequenzen exakt nachzubauen? Gleichzeitig zeigen wir live, wie ein echtes tragbares DNA-Sequenzierungsgerät Gene liest und du erfährst einiges über das menschliche Genom - von bunten Steinen zur modernen Forschung.Medizinische Universität Innsbruck17:00 - 23:00
MitmachstationWie entschlüsselt man DNA - kannst du das auch mit Lego?Thema: Gesundheit NaturwissenschaftenAn dieser interaktiven Station kannst du selbst aus Lego DNA bauen und mit einem Lego-Roboter spielerisch auslesen - schaffst du es Sequenzen exakt nachzubauen? Gleichzeitig zeigen wir live, wie ein echtes tragbares DNA-Sequenzierungsgerät Gene liest und du erfährst einiges über das menschliche Genom - von bunten Steinen zur modernen Forschung.Medizinische Universität Innsbruck17:00 - 23:00 -
 MitmachstationWie erinnert sich unser Gehirn an Kindheitserlebnisse?Thema: Gesundheit NaturwissenschaftenDer Stand bietet Aktivitäten für alle Altersgruppen (z.B. Gehirne ausmalen, eigenen Papierhut in Form eines Gehirns basteln). Die Besucher:innen können sich an einem Quiz zum Thema Gehirn und psychische Gesundheit versuchen und das Gehirn, wie es mit Magnetresonanztomographie (MRT) untersucht wird, entdecken und betrachten.Medizinische Universität Innsbruck17:00 - 23:00
MitmachstationWie erinnert sich unser Gehirn an Kindheitserlebnisse?Thema: Gesundheit NaturwissenschaftenDer Stand bietet Aktivitäten für alle Altersgruppen (z.B. Gehirne ausmalen, eigenen Papierhut in Form eines Gehirns basteln). Die Besucher:innen können sich an einem Quiz zum Thema Gehirn und psychische Gesundheit versuchen und das Gehirn, wie es mit Magnetresonanztomographie (MRT) untersucht wird, entdecken und betrachten.Medizinische Universität Innsbruck17:00 - 23:00 -
 MitmachstationWie funktioniert Massenspektrometrie?Thema: Gesundheit NaturwissenschaftenAnhand von selbst gebastelten Ionenfallen wird durch das Einfangen von frei sichtbaren Partikeln das Prinzip von Massensspektrometrie demonstriert. Zudem wird gezeigt, wie dieses Verfahren in der klinischen Diagnostik zum Einsatz kommt.Medizinische Universität Innsbruck17:00 - 23:00
MitmachstationWie funktioniert Massenspektrometrie?Thema: Gesundheit NaturwissenschaftenAnhand von selbst gebastelten Ionenfallen wird durch das Einfangen von frei sichtbaren Partikeln das Prinzip von Massensspektrometrie demonstriert. Zudem wird gezeigt, wie dieses Verfahren in der klinischen Diagnostik zum Einsatz kommt.Medizinische Universität Innsbruck17:00 - 23:00 -
 Experiment / VorführungWie hören wir? - Station 1: Anatomie und PhysiologieThema: Gesundheit NaturwissenschaftenWie sieht eine menschliche Hörschnecke von Innen aus? Wie analysiert unser Hörorgan die akustische Umgebung? Vom Schall bis zum elektrischen Signal im Hörnerv ist es ein komplexer aber sehr schneller Weg. Hier werden Anatomie und physiologische Vorgänge der Hörschnecke erklärt, und die faszinierende Konstruktion unseres Hörorgans wird durch einen Blick mit dem Mikroskop ins Innenohr veranschaulicht.Medizinische Universität Innsbruck17:00 - 23:00
Experiment / VorführungWie hören wir? - Station 1: Anatomie und PhysiologieThema: Gesundheit NaturwissenschaftenWie sieht eine menschliche Hörschnecke von Innen aus? Wie analysiert unser Hörorgan die akustische Umgebung? Vom Schall bis zum elektrischen Signal im Hörnerv ist es ein komplexer aber sehr schneller Weg. Hier werden Anatomie und physiologische Vorgänge der Hörschnecke erklärt, und die faszinierende Konstruktion unseres Hörorgans wird durch einen Blick mit dem Mikroskop ins Innenohr veranschaulicht.Medizinische Universität Innsbruck17:00 - 23:00 -
 Experiment / VorführungWie hören wir? - Station 2: Grundlagen der HörphysikThema: Gesundheit NaturwissenschaftenWie hören wir unterschiedliche Töne?Medizinische Universität Innsbruck17:00 - 23:00
Experiment / VorführungWie hören wir? - Station 2: Grundlagen der HörphysikThema: Gesundheit NaturwissenschaftenWie hören wir unterschiedliche Töne?Medizinische Universität Innsbruck17:00 - 23:00 -
 MitmachstationWie hören wir? - Station 3: Audiometrie - Wie gut höre ich eigentlich?Thema: Gesundheit NaturwissenschaftenWie wird das Hörvermögen von Babys getestet?Medizinische Universität Innsbruck17:00 - 23:00
MitmachstationWie hören wir? - Station 3: Audiometrie - Wie gut höre ich eigentlich?Thema: Gesundheit NaturwissenschaftenWie wird das Hörvermögen von Babys getestet?Medizinische Universität Innsbruck17:00 - 23:00 -
 Experiment / VorführungWie hören wir? - Station 4: Hörimplantate - Lebensqualität trotz HörverlustThema: Gesundheit NaturwissenschaftenAn dieser Station werden Geräte von Cochlea-Implantaten bis zu Mittelohrimplantaten vorgestellt.Medizinische Universität Innsbruck17:00 - 23:00
Experiment / VorführungWie hören wir? - Station 4: Hörimplantate - Lebensqualität trotz HörverlustThema: Gesundheit NaturwissenschaftenAn dieser Station werden Geräte von Cochlea-Implantaten bis zu Mittelohrimplantaten vorgestellt.Medizinische Universität Innsbruck17:00 - 23:00 -
 Experiment / VorführungWie hören wir? - Station 5: Miniorgane im Reagenzglas für die HNO ForschungThema: Gesundheit NaturwissenschaftenNeben Zellkulturen sind auch komplexere Organoidkulturen und Explantat-Kulturen wichtig für Hör- und Tumorforschung an der HNO. Miniohren und entnommene Tumore in der Petrischale ersetzen Tierversuche und lassen uns beispielsweise die Wirkung von Medikamenten und Gentherapien ermitteln.Medizinische Universität Innsbruck17:00 - 23:00
Experiment / VorführungWie hören wir? - Station 5: Miniorgane im Reagenzglas für die HNO ForschungThema: Gesundheit NaturwissenschaftenNeben Zellkulturen sind auch komplexere Organoidkulturen und Explantat-Kulturen wichtig für Hör- und Tumorforschung an der HNO. Miniohren und entnommene Tumore in der Petrischale ersetzen Tierversuche und lassen uns beispielsweise die Wirkung von Medikamenten und Gentherapien ermitteln.Medizinische Universität Innsbruck17:00 - 23:00 -
 Experiment / VorführungWie kann man Organe drucken?Thema: Gesundheit NaturwissenschaftenAn der Station werden verschiedene 3D Drucker (Filament, Stereolithographie) und ein 3D Biodrucker gezeigt und die Prinzipien des 3D Drucks zur Herstellung von Prototypen und lebender menschlicher Gewebe demonstriert.Medizinische Universität Innsbruck17:00 - 23:00
Experiment / VorführungWie kann man Organe drucken?Thema: Gesundheit NaturwissenschaftenAn der Station werden verschiedene 3D Drucker (Filament, Stereolithographie) und ein 3D Biodrucker gezeigt und die Prinzipien des 3D Drucks zur Herstellung von Prototypen und lebender menschlicher Gewebe demonstriert.Medizinische Universität Innsbruck17:00 - 23:00 -
 Experiment / VorführungWie lassen sich Zellen mit Licht fangen?Thema: Gesundheit NaturwissenschaftenDemonstrationsexperiment Optische PinzetteMedizinische Universität Innsbruck17:00 - 23:00
Experiment / VorführungWie lassen sich Zellen mit Licht fangen?Thema: Gesundheit NaturwissenschaftenDemonstrationsexperiment Optische PinzetteMedizinische Universität Innsbruck17:00 - 23:00 -
 MitmachstationWie lässt sich Krebs besser verstehen und somit bekämpfen?Thema: Gesundheit NaturwissenschaftenWerfen Sie einen Blick auf die von uns zur DNA-Vervielfältigung verwendeten Bakterien, die wir für Sie zum Leuchten gebracht haben. Zusätzlich führen wir exemplarisch eine weitere wichtige Methode unserer Arbeit vor, informieren über die Grundlagenforschung im Bereich der Krebstherapie und darüber, welche Rolle Viren dabei spielen. Gerne beantworten wir Fragen zu diesem wichtigen Thema.Medizinische Universität Innsbruck17:00 - 23:00
MitmachstationWie lässt sich Krebs besser verstehen und somit bekämpfen?Thema: Gesundheit NaturwissenschaftenWerfen Sie einen Blick auf die von uns zur DNA-Vervielfältigung verwendeten Bakterien, die wir für Sie zum Leuchten gebracht haben. Zusätzlich führen wir exemplarisch eine weitere wichtige Methode unserer Arbeit vor, informieren über die Grundlagenforschung im Bereich der Krebstherapie und darüber, welche Rolle Viren dabei spielen. Gerne beantworten wir Fragen zu diesem wichtigen Thema.Medizinische Universität Innsbruck17:00 - 23:00 -
 MitmachstationWie schaut ein Eiweißmolekül aus?Thema: Gesundheit NaturwissenschaftenAuf einem Computer wird ein Eiweißmolekül in dreidimensionaler Darstellung gezeigt. Man kann per Maus das Molekül drehen, stürzen, zoomen, in der Farbe verändern, einzelne Atome darstellen sowie einzelne Aminosäuren kennzeichnen, insbesondere wenn sie mutiert sind. Das ist sowohl spannend wie auch lehrreich.Medizinische Universität Innsbruck17:00 - 23:00
MitmachstationWie schaut ein Eiweißmolekül aus?Thema: Gesundheit NaturwissenschaftenAuf einem Computer wird ein Eiweißmolekül in dreidimensionaler Darstellung gezeigt. Man kann per Maus das Molekül drehen, stürzen, zoomen, in der Farbe verändern, einzelne Atome darstellen sowie einzelne Aminosäuren kennzeichnen, insbesondere wenn sie mutiert sind. Das ist sowohl spannend wie auch lehrreich.Medizinische Universität Innsbruck17:00 - 23:00 -
 MitmachstationWie werden Naturstoffe aus Korallen im Labor nachgebaut und warum ist das wichtig für die Entwicklung neuer Medikamente?Thema: Gesundheit NaturwissenschaftenWeichkorallen sind eine wertvolle Quelle bioaktiver Naturstoffe. Eine direkte Gewinnung dieser Stoffe aus der Natur wäre ökologisch problematisch und würde stark in das sensible Korallen-Ökosystem eingreifen. Wir zeigen, wie Forschende mithilfe moderner synthetischer, spektroskopischer und spektrometrischer Methoden der Organ. Chemie diese Naturstoffe im Labor nachbilden, untersuchen und nachhaltig verfügbar machen.Universität Innsbruck17:00 - 23:00
MitmachstationWie werden Naturstoffe aus Korallen im Labor nachgebaut und warum ist das wichtig für die Entwicklung neuer Medikamente?Thema: Gesundheit NaturwissenschaftenWeichkorallen sind eine wertvolle Quelle bioaktiver Naturstoffe. Eine direkte Gewinnung dieser Stoffe aus der Natur wäre ökologisch problematisch und würde stark in das sensible Korallen-Ökosystem eingreifen. Wir zeigen, wie Forschende mithilfe moderner synthetischer, spektroskopischer und spektrometrischer Methoden der Organ. Chemie diese Naturstoffe im Labor nachbilden, untersuchen und nachhaltig verfügbar machen.Universität Innsbruck17:00 - 23:00 -
 Experiment / VorführungWie wird Energie bei chemischen Reaktionen entfesselt?Thema: NaturwissenschaftenSpektakuläre chemische Experimentalvorlesungen haben eine lange Tradition. Schon Justus von Liebig begeisterte sein Publikum mit der Verbindung von Wissenschaft und Unterhaltung. In dieser Tradition zeigt der Vortrag die Entfesselung chemisch gebundener Energie durch Farbreaktionen, spektakuläre Verbrennungen und eindrucksvolle Explosionen.Universität Innsbruck17:00 - 23:00
Experiment / VorführungWie wird Energie bei chemischen Reaktionen entfesselt?Thema: NaturwissenschaftenSpektakuläre chemische Experimentalvorlesungen haben eine lange Tradition. Schon Justus von Liebig begeisterte sein Publikum mit der Verbindung von Wissenschaft und Unterhaltung. In dieser Tradition zeigt der Vortrag die Entfesselung chemisch gebundener Energie durch Farbreaktionen, spektakuläre Verbrennungen und eindrucksvolle Explosionen.Universität Innsbruck17:00 - 23:00 -
 MitmachstationWo kommt DNA eigentlich vor und wie kann man sie sichtbar machen?Thema: Gesundheit NaturwissenschaftenHerzlich Willkommen an der DNA-Station! Hier kannst Du mit Hilfe von einfachen Haushaltsutensilien DNA aus verschiedenen Lebensmitteln gewinnen. Gleichzeitig schauen wir uns DNA direkt in Zwiebelzellen an und Du erfährst, wie die DNA aufgebaut ist und wie sie innerhalb und außerhalb der Zelle aussieht.Medizinische Universität Innsbruck17:00 - 23:00
MitmachstationWo kommt DNA eigentlich vor und wie kann man sie sichtbar machen?Thema: Gesundheit NaturwissenschaftenHerzlich Willkommen an der DNA-Station! Hier kannst Du mit Hilfe von einfachen Haushaltsutensilien DNA aus verschiedenen Lebensmitteln gewinnen. Gleichzeitig schauen wir uns DNA direkt in Zwiebelzellen an und Du erfährst, wie die DNA aufgebaut ist und wie sie innerhalb und außerhalb der Zelle aussieht.Medizinische Universität Innsbruck17:00 - 23:00 -
 FührungWohin geht die Reise? Frühgeborenen-Intensivmedizin im Jahr 2026Thema: Gesundheit NaturwissenschaftenBesuchen Sie in Kleingruppen gemeinsam die Frühgeborenen Intensiv- und Nachsorgestation.Medizinische Universität Innsbruck17:00 - 23:00
FührungWohin geht die Reise? Frühgeborenen-Intensivmedizin im Jahr 2026Thema: Gesundheit NaturwissenschaftenBesuchen Sie in Kleingruppen gemeinsam die Frühgeborenen Intensiv- und Nachsorgestation.Medizinische Universität Innsbruck17:00 - 23:00











